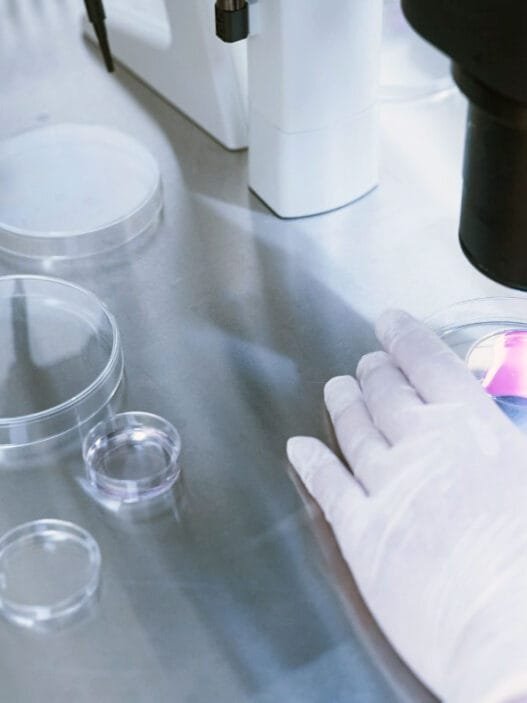
İlaçsız Tüp Bebek Tedavisi

Aşılama (inseminasyon), çocuk sahibi olmakta zorlanan çiftler için umut verici bir yardımcı üreme yöntemidir. Bu rehberde aşılama süreci, hangi durumlarda tercih edildiği ve tedavi öncesi-sonrası dikkat edilmesi gereken tüm detayları bulacaksınız. Aşılama, doğal yollarla gebelik sağlanamadığında gebelik şansını artırmanın etkili bir yoludur.
- Aşılama Tedavisi: Tanımı ve Önemi
- Aşılama Tedavisi Neden Tercih Edilir?
- Aşılama Tedavisinin Uygulanamayacağı Durumlar
- Aşılama Tedavisinin Uygulama Zamanı
- Aşılama Tedavisi İçin Uygun Kişiler
- Aşılama Tedavisi Öncesi Hazırlık
- Aşılama Tedavisinin Uygulama Aşamaları
- Aşılama Sonrası Cinsel Yaşam
- Aşılama Tedavisinin Başarı Oranı ve Tekrarı
- Aşılama ve Tüp Bebek Tedavisi: Temel Farklar
- Aşılama Tedavisinde Başarıyı Belirleyen Faktörler
- Sıkça Sorulan Sorular (SSS)
Aşılama Tedavisi: Tanımı ve Önemi
Aşılama (inseminasyon), çocuk sahibi olmak isteyen ve doğal yollarla gebelik elde edemeyen çiftlerin sıklıkla başvurduğu bir yardımcı üreme yöntemidir. Bu yöntem, erkeğin spermlerinin laboratuvar ortamında özel işlemlerden geçirilip, kadının rahmine yerleştirilmesi işlemidir. Aşılama, özellikle erkek faktörüne bağlı infertilite, rahim ağzı problemleri, sperm sayısında veya hareketliliğinde düşüklük gibi durumlar söz konusu olduğunda tercih edilir. Aşılama, doğal üremeye en yakın yöntemlerden biridir ve gebelik şansını artırmak için kullanılır.
Aşılama Tedavisi Neden Tercih Edilir?
Aşılama tedavisi, doğal yollarla gebelik sağlanamadığında gebelik şansını artırmak amacıyla uygulanır. Aşılama, erkeğin spermlerinin laboratuvarda özel yöntemlerle işlenerek kadının rahmine yerleştirilmesiyle gebelik oluşumuna yardımcı olur. Bu yöntem, özellikle erkek faktörü veya rahim ağzı problemleri gibi durumlarda tercih edilir.
Aşılama Tedavisinin Uygulanamayacağı Durumlar
Aşılama tedavisinin uygulanamayacağı bazı durumlar vardır. Eğer kadının fallop tüpleri tıkalıysa, ileri derecede endometriozis söz konusuysa ya da erkeğin sperm sayısı ve kalitesi çok düşükse aşılama yerine farklı üreme teknikleri tercih edilmelidir. Ayrıca kadının yaşı ileri düzeydeyse veya yumurta rezervi azalmışsa, aşılama tedavisi yerine tüp bebek tedavisi daha uygun olabilir.
Aşılama Tedavisinin Uygulama Zamanı
Aşılama tedavisi, kadının yumurtlama dönemi sırasında yapılmalıdır. Yumurtlama dönemi, kadının gebelik şansının en yüksek olduğu dönemdir. Bu nedenle yumurtlama zamanı, doktor tarafından ultrason ve hormon testleriyle takip edilerek belirlenir. Yumurtlama döneminde, erkekten alınan spermler özel işlemlerden geçirilerek rahme enjekte edilir.
Aşılama Tedavisi İçin Uygun Kişiler
Aşılama tedavisi, genellikle aşağıdaki durumlarda uygulanmaktadır:
- Kadın yaşı 35’ten gençse ve yumurta rezervi iyi durumdaysa,
- Rahim tüpleri açık ve sağlıklıysa,
- Erkekte sperm sayısı ve hareketliliği yeterliyse (özellikle 5 milyonun üzerinde hareketli sperm varsa),
- Açıklanamayan kısırlık durumunda ya da hafif sperm kalitesi sorunlarında aşılama tercih edilebilir.
Aşılama Tedavisi Öncesi Hazırlık
Aşılama tedavisine başlamadan önce hem kadın hem de erkek için bazı testler yapılır. Bu testler, çiftin aşılama tedavisi için uygun olup olmadığını belirlemek adına önemlidir. Kadınlarda HSG (rahim filmi) ile tüplerin açık olup olmadığı kontrol edilirken, erkeklerde spermiogram testi ile sperm sayısı, hareketliliği ve morfolojisi değerlendirilir. Aşılama öncesi dikkat edilmesi gereken diğer noktalar şunlardır:
- Yumurtlama Uyarıcı İlaçlar: Kadının yumurtlamasını desteklemek için adetin 2. veya 3. gününde yumurta uyarıcı ilaçlar kullanılabilir. Bu ilaçlar, yumurtanın olgunlaşmasına ve aşılama için uygun hale gelmesine yardımcı olur.
- Cinsel Perhiz: Erkekten alınacak sperm örneğinin kalitesini artırmak için aşılama öncesi 2-5 gün cinsel perhiz uygulanmalıdır.
- Yaşam Tarzı Değişiklikleri: Aşılama öncesinde hem kadın hem de erkeğin sağlıklı beslenmeye dikkat etmesi, stresten uzak durması ve alkol gibi zararlı alışkanlıklardan kaçınması önerilir.
Aşılama Tedavisinin Uygulama Aşamaları
Aşılama tedavisinde ilk olarak kadının yumurtlama dönemi tespit edilir. Gebelik oluşması için kadının yumurtlama döneminde olması, yani yumurta hücresinin döllenmeye uygun hale gelmiş olması önemlidir. Yumurtlama döneminde, erkekten alınan spermler özel solüsyonlarla yıkanır ve en sağlıklı spermler seçilir. Ardından, kadının vajinasına spekulum adı verilen bir alet yerleştirilir ve bir kateter yardımıyla seçilen spermler rahmin içine bırakılır. Bu işlem ağrısız olup, genellikle anestezi gerektirmez ve yaklaşık 15-20 dakika sürer. Aşılamadan sonra kadınların 15 dakika kadar dinlenmeleri yeterlidir.
Aşılama Sonrası Cinsel Yaşam
Aşılama tedavisi sonrası cinsel ilişki konusunda genellikle bir kısıtlama bulunmamaktadır. Aşılama işleminden sonra birkaç gün cinsel ilişki yaşanabilir. Bu süreçte aşırı zorlayıcı aktivitelerden kaçınmak ve doktorun önerilerine uymak önemlidir. Cinsel ilişki, aşılama sürecinde spermlerin yumurtaya ulaşmasını destekleyebilir.
Aşılama Tedavisinin Başarı Oranı ve Tekrarı
Aşılama tedavisinin başarı oranı, çiftin yaşına, kısırlığın nedenine ve kullanılan tedavi yöntemine göre değişiklik gösterir. Genel olarak aşılama ile gebelik oranı %10-20 arasındadır. Ancak bu oran, kadının yaşı ilerledikçe ve yumurta rezervi azaldıkça düşebilir. Aşılama tedavisi genellikle 3-4 kez denenebilir. Eğer bu denemelerde gebelik elde edilemezse, çiftin tüp bebek tedavisine yönlendirilmesi önerilir.
Aşılama ve Tüp Bebek Tedavisi: Temel Farklar
Aşılama ve tüp bebek tedavisi, her ikisi de yardımcı üreme yöntemleridir ancak aralarında bazı temel farklar vardır. Aşılama tedavisinde döllenme, kadının fallop tüplerinde gerçekleşir ve spermler doğrudan rahme enjekte edilir. Tüp bebek tedavisinde ise yumurta ve sperm laboratuvar ortamında döllenir ve oluşan embriyo rahme transfer edilir. Kadının yaşı, yumurta rezervi ve kısırlığın nedeni, bu iki yöntemden hangisinin tercih edileceğini belirlemede önemli rol oynar.
Aşılama Tedavisinde Başarıyı Belirleyen Faktörler
- Kadının yaşı: Genç yaşta yapılan aşılamaların başarı oranı daha yüksektir.
- Sperm Kalitesi: Yüksek hareketli sperm sayısı, başarı oranını artırır.
- İnfertilite Süresi: Kısırlık süresi uzadıkça aşılama ile gebelik şansı azalabilir.
- Tüp Sağlığı: Fallop tüplerinin açık ve sağlıklı olması aşılama için kritik önem taşır.
Sıkça Sorulan Sorular (SSS)
Aşılama işlemi ağrılı mıdır?
Aşılama işlemi genellikle ağrısız bir işlemdir. Bazı kadınlar hafif rahatsızlık veya kramplar hissedebilir, ancak bu durum kısa süreli ve hafiftir.
Aşılama sonrası ne zaman gebelik testi yapılmalıdır?
Aşılamadan yaklaşık 2 hafta sonra gebelik testi yapılmalıdır. Bu süre, embriyonun rahme tutunması ve HCG hormonunun ölçülebilir seviyeye ulaşması için gereklidir.
Aşılama kaç kez denenebilir?
Aşılama genellikle 3-4 kez denenir. Bu denemelerde gebelik oluşmazsa tüp bebek tedavisi önerilir.
Aşılama tedavisinde başarı oranı nedir?
Aşılama tedavisinde başarı oranı %10-20 civarındadır ve kadının yaşı, sperm kalitesi gibi faktörlere bağlı olarak değişir.
Aşılama ile tüp bebek arasındaki fark nedir?
Aşılama, spermin doğrudan rahme enjekte edilmesidir. Tüp bebekte ise yumurta ve sperm laboratuvarda döllenir ve embriyo rahme transfer edilir.